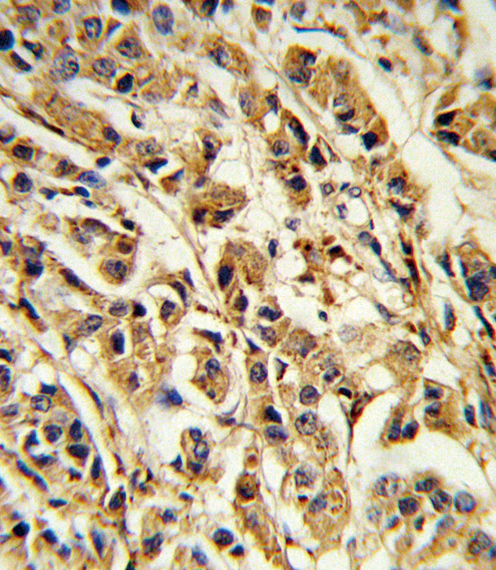

> Antigen, Antibodies, ELISA, Western Blot > Primary Antibody > Polyclonal Antibodies > SREBF1 Antibody (Center)Brand |
Leading Biology | Catalog Number |
APR10237G |
Product Type |
Polyclonal Antibodies | Field of Research |
|
Product Overview |
We constantly strive to ensure we provide our customers with the best antibodies. As a result of this work we offer this antibody in purified format.
We are in the process of updating our datasheets. If you have any questions regarding this update, please feel free to contact our technical support team.
This product is a high quality SREBF1 antibody (Center).
|
||
Molecular Weight |
121675 Da
|
||
Cellular Localization |
Antigen Cellular Localization:
Endoplasmic reticulum membrane; Multi-pass membrane protein. Golgi apparatus membrane; Multi-pass membrane protein. Cytoplasmic vesicle, COPII-coated vesicle membrane; Multi-pass membrane protein. Note=Moves from the endoplasmic reticulum to the Golgi in the absence of sterols Isoform SREBP-1aDelta: Nucleus {ECO:0000255|PROSITE-ProRule:PRU00981, ECO:0000269|PubMed:18267114}
|
||
Host |
Rabbit
|
||
Species Reactivity |
Human
|
||
Immunogen |
349-378 aa
|
||
Target |
This SREBF1 antibody is generated from rabbits immunized with a KLH conjugated synthetic peptide between 349-378 amino acids from the Central region of human SREBF1.
|
||
Isotype |
Rabbit Ig
|
||
Symbol |
BHLHD1, SREBP1
|
||
GeneID |
|||
UniProt ID |
|||
Function |
Transcriptional activator required for lipid homeostasis. Regulates transcription of the LDL receptor gene as well as the fatty acid and to a lesser degree the cholesterol synthesis pathway (By similarity). Binds to the sterol regulatory element 1 (SRE-1) (5'-ATCACCCCAC-3'). Has dual sequence specificity binding to both an E-box motif (5'-ATCACGTGA-3') and to SRE-1 (5'-ATCACCCCAC-3').
|
||
Summary |
SREBF1 is a transcription factor that binds to the sterol regulatory element-1 (SRE1), which is a decamer flanking the low density lipoprotein receptor gene and some genes involved in sterol biosynthesis. The protein is synthesized as a precursor that is attached to the nuclear membrane and endoplasmic reticulum. Following cleavage, the mature protein translocates to the nucleus and activates transcription by binding to the SRE1. Sterols inhibit the cleavage of the precursor, and the mature nuclear form is rapidly catabolized, thereby reducing transcription. The protein is a member of the basic helix-loop-helix-leucine zipper (bHLH-Zip) transcription factor family.
|
||
Form |
Purified polyclonal antibody supplied in PBS with 0.09% (W/V) sodium azide. This antibody is purified through a protein A column, followed by peptide affinity purification. |
||
Storage & Stability |
Store at +4°C short term. For long-term storage, aliquot and store at -20°C or below. Stable for 12 months at -20°C. Avoid repeated freeze-thaw cycles.
|
||
Applications |
WB, IHC-P, FC, E
|
||
Dilution |
WB~~1:1000
IHC-P~~1:10~50
FC~~1:10~50
|
||
Synonyms |
Sterol regulatory element-binding protein 1, SREBP-1, Class D basic helix-loop-helix protein 1, bHLHd1, Sterol regulatory element-binding transcription factor 1, Processed sterol regulatory element-binding protein 1, SREBF1, BHLHD1, SREBP1
|
||
Images |

Anti-SREBF1 Antibody (Center) at 1:1000 dilution + Jurkat whole cell lysate Lysates/proteins at 20 μg per lane. Secondary Goat Anti-Rabbit IgG, (H+L), Peroxidase conjugated at 1/10000 dilution. Predicted band size : 122 kDa Blocking/Dilution buffer: 5% NFDM/TBST. 
Western blot analysis of SREBF1 Antibody (Center) (Cat. APR10237G) in MDA-MB435 cell line lysates (35ug/lane). SREBF1 (arrow) was detected using the purified Pab.
Formalin-fixed and paraffin-embedded human breast carcinoma reacted with SREBF1 Antibody (Center), which was peroxidase-conjugated to the secondary antibody, followed by DAB staining. This data demonstrates the use of this antibody for immunohistochemistry; clinical relevance has not been evaluated. |
||
Specification |
|||
Quantity |
|
||
| Select | Brand | Catalog No. | Product Name | Pack Size | Type | Field of Research | Specification | Quantity | Price(USD) | |
| 1 | Leading Biology | APR03440G | ITGA11 Antibody (N-term) | 100 μl | Polyclonal Antibodies |
|
$495.00 | Add Ask | ||
| 2 | Leading Biology | APR04537G | CMIP Antibody (C-term) | 100 μl | Polyclonal Antibodies |
|
$495.00 | Add Ask | ||
| 3 | Leading Biology | APR12422G | Human H4 Histamine Receptor (extracellular) Antibody | 50 μl | Polyclonal Antibodies |
|
$695.00 | Add Ask | ||
| 4 | Leading Biology | APR03844G | UBE2W Antibody (C-term) | 100 μl | Polyclonal Antibodies |
|
$495.00 | Add Ask | ||
| 5 | Leading Biology | APR04349G | HECTD2 Antibody (N-term) | 100 μl | Polyclonal Antibodies |
|
$495.00 | Add Ask | ||
| 6 | Leading Biology | APR03502G | IGHG1 Antibody (Center) | 100 μl | Polyclonal Antibodies |
|
$495.00 | Add Ask |
 Leading Biology Inc.
2600 Hilltop DR, Building G, B Suite C138
Richmond, CA, 94806
Tel: 1-661-524(LBI)-0262
Email: info@leadingbiology.com
Leading Biology Inc.
2600 Hilltop DR, Building G, B Suite C138
Richmond, CA, 94806
Tel: 1-661-524(LBI)-0262
Email: info@leadingbiology.com
Complete this form and click send to ask us a question, request a quote or simply say hello.

You have 0 item in your cart

You have 0 item in your inquiry list
